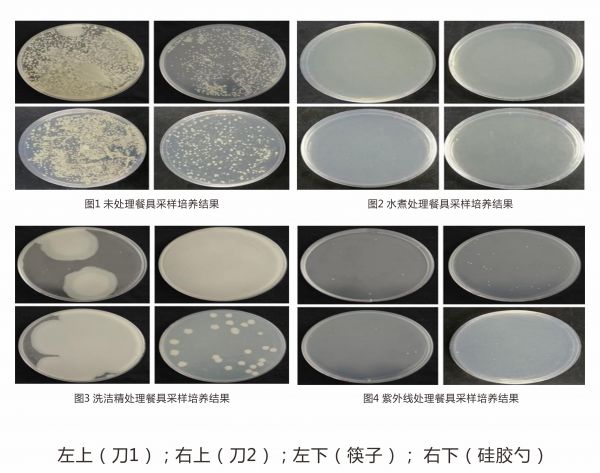
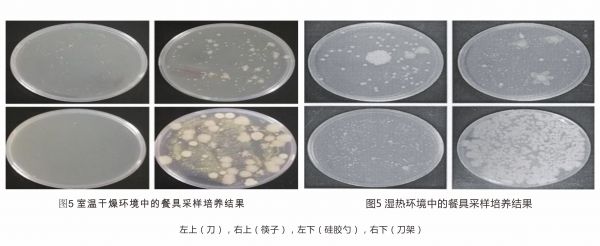

为什么说火鸡消毒刀架是品类的开创者
为什么说火鸡消毒刀架是品类的开创者?
如果吃西瓜吃出了大蒜味,如果吃苹果吃出了洋葱味。这不是食物本身的问题,这可能与我们的某些生活习惯有关。比如我们用刚切完大蒜的刀来切西瓜,刚切完洋葱的砧板来切苹果。在使用餐具前,我们会习惯性的用水冲一下,但是真的很少能将餐具冲洗干净,或许我们肉眼看不到,但细菌和味道却是真实存在,并且交叉感染。特别是在炎热的夏日,细菌繁殖迅速,这种味道会越发强烈。

常规清洗无法将餐具完全清洗干净,依然残留细菌
日常我们习惯用水冲、用洗洁精清洗、用水煮,还有少部分人会用柠檬和盐或者醋来清洗,但其实这些方法都无法全部杀死细菌,仍然有部分有害微生物残留在刀具、筷子、砧板上。
其实筷子本身并不会长黄曲霉菌,但我们平时使用筷子来吃花生、玉米等淀粉含量高的食物时,筷子缝里最容易藏淀粉,养料有了,水,温度适宜,黄曲霉素就藏在里面了。砧板和刀具也是细菌繁殖的重要基地,上面的微生物,食物残渣中的水分和营养物质含量很高,非常适合细菌生长,繁殖。切完生肉之后,刀具和砧板如果不进行彻底清洁就会造成交叉感染。砧板比马桶座的危险细菌多好几十倍。

这些真菌、细菌、病毒无一不是健康的杀手。甚至你放在那里看似洗干净的的餐具,实际依然是细菌聚集地,而细菌之间又会进行相互传染。这对于我们普通人来说,无疑是一大健康安全隐患。
中科院浙江工商大学食品营养科学联合研究中心发起实验
就在今年5月,浙江工商大学现代食品安全与营养协同创新中心中科院浙江工商大学食品营养科学联合研究中心做过两个实验,一个是日常餐具清洗消毒方法的效果对比实验,第二个是基于日常餐具放置环境进行对比实验。
实验一
按照预设的4种处理方式(未清洗、开水煮、普通冲洗晾干、紫外线消毒)和提供的来源于厨房的4组一样的餐具(即每组2把刀,3双筷子,1个硅胶勺)
总结:综合菌落计数和菌落外观检视,三种处理方式与未处理组相比,餐具上的微生物均显著减少;其中,水煮处理和紫外线照射均取得了良好的灭菌效果,均明显优于洗洁精清洗组。
实验二
为检验未灭菌的旧刀架是否会造成清洁灭菌后的刀具和餐具的二次污染,以及在干燥或潮湿环境下二次污染的程度是否有差别,将刀餐具与未灭菌的旧刀架一起分别置于一般干燥环境(室温24℃左右,环境湿度40~50%)和湿热环境(温度30℃,湿度80%),并根据提供的来源于厨房的1组同样的刀具餐具(即2把刀,3双筷子,1个硅胶勺,1个刀架)
结论2:综合菌落计数和菌落外观检视,硅胶勺在湿热环境中的微生物滋生数量高于室温干燥环境,其它各组虽然菌落计数两组间无显著差异,但湿热环境中的菌落形态显著大于室温干燥环境,提示湿热环境可能促进了微生物生物膜形成,有可能增加条件致病菌的污染风险。
通过第一个实验,可以看出水煮处理和紫外线照射杀菌效果显著,当然紫外线照射比水煮更方便。从实验二来看,餐具摆放的环境湿度和温度也是直接原因,不合理的摆放方式更容易使细菌相互传染。
紫外线的有效杀菌成果,促使消毒刀架新品类的出现
值得庆幸杀的是,在小家电赛道里,目前已经出现了能给餐具有效杀菌的消毒刀架,其原理就是利用紫外线杀菌和热风烘干两种方式相配合。

所谓紫外线杀菌灯发出的就是UVC短波紫外线,可杀死水中所有细菌,其杀伤力可达98%,特别是285nmUVC波段,波长100~275nm,又称为短波灭菌紫外线。如果日常使用的餐具用这种纯物理消毒方法,具有简单便捷、广谱高效、无二次污染、便于管理和实现自动化等优点。
火鸡消毒刀架成为品类代表
早在2018年,疫情还未开始,火鸡电器便注意到了餐具卫生问题,并开始着手大量的前期调研工作,发现大部分消费者的消费水平都很高,各种生活理念也与父辈有所区别,大家也很愿意为优质健康的产品买单。火鸡电器为了满足人们对健康品质生活的新需求,通过把握商业发展趋势,发现品类机会,率先着手消毒刀架的研发。

火鸡消毒刀架主要利用紫外线照射消毒杀菌,再配合70-75度的高温热风烘干,在干燥的环境下进行餐具的杀菌烘干。并拥有四项核心专利:全方位无死角UVC紫外线杀菌装、360度立体热风循环烘干系统、自动杀菌定时巡航系统、刀具插拔自动识别检测装置,也形成了UVC原件、杀菌灯排布和干燥高温环境三者共同作用提高杀菌率的方式及其他细分门类专利。
产品一上市便受广大消费者追捧,市场反馈也很直接。特别是在疫情的推动下,强化了人们对健康产品的消费意识,对火鸡消毒刀架的销量也有了很大的推动作用,使得火鸡消毒刀架销售额直线上升,一跃而成为了消费者心智中的品类代表,持续占消毒刀架品类主导地位。同时,火鸡电器注重研发和用户反馈不断的推动着消毒刀架品类发展,火鸡电器也算是健康小家电中的独角兽水平。
网址:为什么说火鸡消毒刀架是品类的开创者 https://www.jiaju82.com/news-view-id-712779.html

